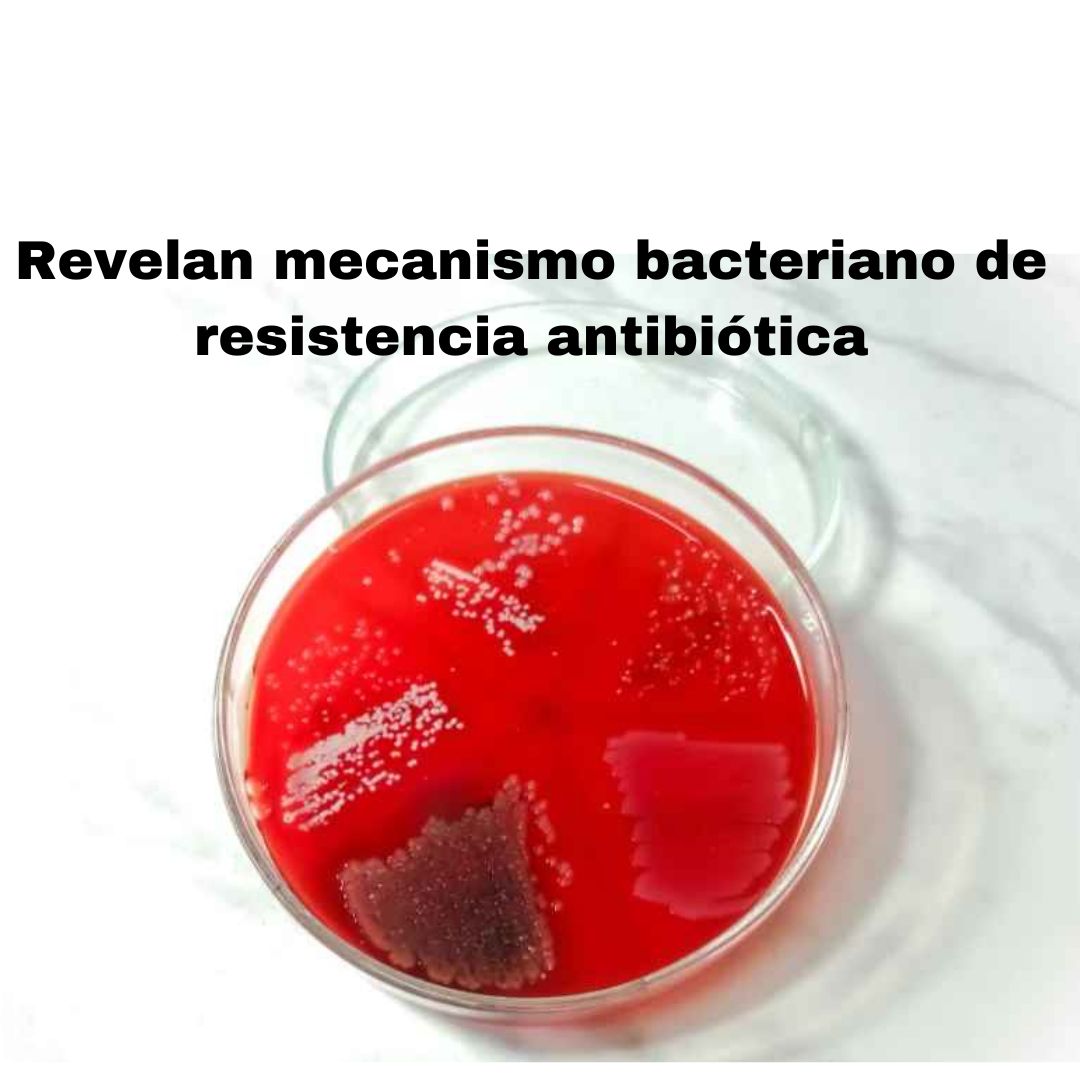

El nuevo mecanismo ha sido denominado perseverancia antibiótica, y puede promover la mutación de bacterias hacia cepas resistentes.
La resistencia a los antimicrobianos (RAM) y el aumento de bacterias multirresistentes se encuentran entre las amenazas más importantes para la salud pública en todo el mundo, según la Organización Mundial de la Salud (OMS).
La perseverancia bacteriana es un nuevo fenómeno que ayuda a explicar cómo las bacterias se adaptan para sobrevivir a los tratamientos con antibióticos.
Un grupo de investigadores ha estudiado cómo reaccionan las bacterias individuales cuando se exponen a diferentes antibióticos. El resultado subraya la importancia de cumplir estrictamente con las prescripciones de antibióticos.
La lucha contra las enfermedades bacterianas es “una carrera armamentista perpetua entre los científicos que desarrollan nuevas terapias y las bacterias patógenas que cambian continuamente su composición genética para sobrevivir a los medicamentos”, comentan.
Cuando se inicia el tratamiento antibacteriano, la alta concentración de antibióticos mata a la mayoría de las bacterias o evita que crezcan casi de inmediato. Por ello, el paciente mejora sus síntomas clínicos a los pocos días del tratamiento, pero la rápida recuperación puede albergar bacterias con potencial suficiente para seguir replicándose.
“Estas bacterias no son resistentes”, indican los autores del estudio, pero pueden continuar dividiéndose a pesar de una concentración relativamente alta de antibióticos debido a las variaciones naturales en la cepa bacteriana. Los investigadores han demostrado que estas fracciones de las bacterias a menudo continúan creciendo, a veces hasta 10 generaciones.
No obstante, aunque no sean bacterias resistentes, “cada división celular le da a la bacteria la oportunidad de mutar y convertirse en una cepa que sea permanentemente resistente”. Sin embargo, “este es un evento raro”, por lo que “si completa el tratamiento antibiótico completo, tiene grandes posibilidades de eliminar la infección”.
“Este es un nuevo concepto que llamamos perseverancia antibiótica”, explican. “La perseverancia describe cómo un pequeño grupo de bacterias capaces de sostener el crecimiento pueden acumular mutaciones después de haber sido expuestas a antibióticos. Si tienen suerte, y el paciente tiene mala suerte, una de estas mutaciones les permitirá tolerar el antibiótico”.
Cuando los investigadores estudian las bacterias, normalmente observan la población bacteriana en su conjunto, es decir, estudian la respuesta colectiva de muchas bacterias. Dado que las “bacterias perseverantes son muy raras, hasta ahora han escapado a la atención”. Por ello, este estudio muestra “la importancia de no generalizar, incluso cuando se trata de bacterias".
Fuente: https://www.diarioveterinario.com/
TAGS: Perseverancia antibiótica. Mutación de bacterias. Cepas resistentes. Resistencia a los antimicrobianos. Salud pública. Una Salud. One Health.

Impecable artículo y la otra lucha es manejar el uso de ATBs en la metafilaxia al ingreso al feedlot. Por las dudas, inyecto. No debe hacerse en forma indiscriminada.